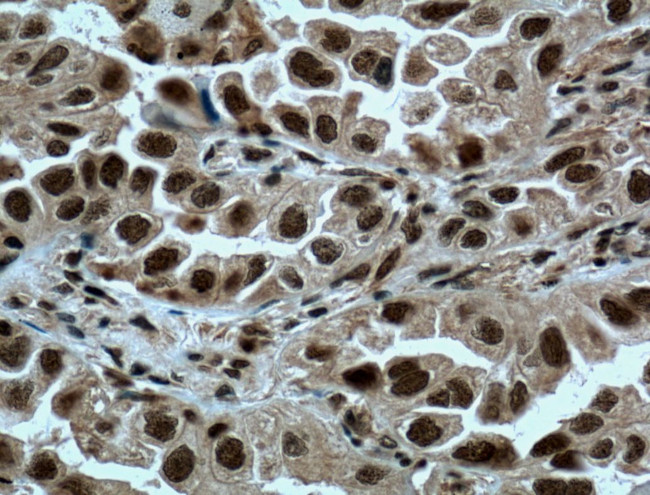
METTL3 Antibody in Immunohistochemistry (Paraffin) (IHC (P))
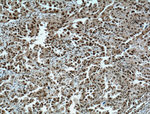
METTL3 Antibody in Immunohistochemistry (Paraffin) (IHC (P))

Search
Proteintech
METTL3 Polyclonal Antibody
{{$productOrderCtrl.translations['antibody.pdp.commerceCard.promotion.promotions']}}
{{$productOrderCtrl.translations['antibody.pdp.commerceCard.promotion.viewpromo']}}
{{$productOrderCtrl.translations['antibody.pdp.commerceCard.promotion.promocode']}}: {{promo.promoCode}} {{promo.promoTitle}} {{promo.promoDescription}}. {{$productOrderCtrl.translations['antibody.pdp.commerceCard.promotion.learnmore']}}
产品信息
15073-1-AP
种属反应
已发表种属
宿主/亚型
分类
类型
抗原
偶联物
形式
浓度
规格
纯化类型
保存液
内含物
保存条件
运输条件
产品详细信息
Immunogen sequence: LNQQSTKEQ QSKKVSQEIL ELLNTTTAKE QSIVEKFRSR GRAQVQEFCD YGTKEECMKA SDADRPCRKL HFRRIINKHT DESLGDCSFL NTCFHMDTCK YVHYEIDACM DSEAPGSKDH TPSQELALTQ SVGGDSSADR LFPPQWICCD IRYLDVSILG KFAVVMADPP WDIHMELPYG TLTDDEMRRL NIPVLQDDGF LFLWVTGRAM ELGRECLNLW GYERVDEIIW VKTNQLQRII RTGRTGHWLN HGKEHCLVGV KGNPQGFNQG LDCDVIVAEV RSTSHKPDEI YGMIERLSPG TRKIELFGRP HNVQPNWITL GNQLDGIHLL DPDVVARFKQ RYPDGIISKP KNL (229-580 aa encoded by BC001650)
靶标信息
METTL3 is the 70 kDa subunit of MT-A which is part of N6-adenosine-methyltransferase. This enzyme is involved in the posttranscriptional methylation of internal adenosine residues in eukaryotic mRNAs, forming N6-methyladenosine.
仅用于科研。不用于诊断过程。未经明确授权不得转售。
生物信息学
蛋白别名: adoMet-binding subunit of the human mRNA (N6-adenosine)-methyltransferase; hMETTL3; m6a methyltransferase; methyltransferase like 3; methyltransferase-like 3; Methyltransferase-like protein 3; mRNA (2'-O-methyladenosine-N(6)-)-methyltransferase; mRNA m(6)A methyltransferase; MT-A70; N(6)-adenosine-methyltransferase 70 kDa subunit; N(6)-adenosine-methyltransferase catalytic subunit METTL3; N6-adenosine-methyltransferase 70 kDa subunit; N6-adenosine-methyltransferase subunit METTL3; unnamed protein product
基因别名: 2310024F18Rik; hMETTL3; IME4; M6A; METTL3; MT-A70; MTA70; Spo8
UniProt ID: (Human) Q86U44, (Mouse) Q8C3P7
Entrez Gene ID: (Human) 56339, (Mouse) 56335, (Rat) 361035